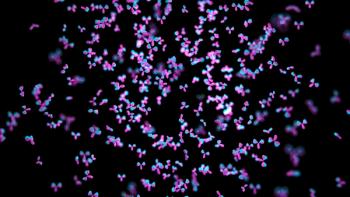

Experiments conducted by the downstream technology team at Spark Therapeutics involving metal ion-containing additives showed improved capsid clearance in AAV production.

Experiments conducted by the downstream technology team at Spark Therapeutics involving metal ion-containing additives showed improved capsid clearance in AAV production.

The authors evaluated the potential of direct filtration for multiple biopharmaceutical candidates. This article is Part 2 of the study.

Purolite and Repligen have commercially launched a new CH1 affinity resin for the purification of specialized mAbs.

The authors present a methodology to assess the contribution of individual filters to overall capacity of the direct filtration train, and elucidate how capacity is affected by characteristics of the cell culture broth and process parameters, including for enhanced upstream processes such as those incorporating high cell density perfusion.

The 3M Harvest RC Chromatographic Clarifier, BT500 is the latest addition to the company’s chromatographic clarifier portfolio.

USP offers strategies to minimize residual impurities in downstream processing.

The innovation of affinity ligands must take stability into consideration for present and future purification applications.

Innovations in downstream processing accelerate development, enhance efficiency, and promote sustainability.

In this article, a simple chromatographic model is proposed that is capable of predicting the impact of pH and ionic strength on HIC chromatograms.

Downstream processing will continue to see shifts with the incorporation of modern, efficient technologies.

The services are based on the company’s PurePrep EasyClean (PEC) orthogonal peptide purification technology.

Sartorius BIA Separations and Teknova will collaborate to combine their technologies in an effort to streamline the downstream purification process.

In part 2 of this article, results from the testing of a next generation convecdiff membrane are discussed.

The testing of new convecdiff membranes shows this material to be well suited for lab- and commercial-scale bind-and-elute applications.

The design of viral clearance studies must keep pace with the quickly evolving biologic drugs industry.

Thanks to technological advances, process chromatography challenges are surmountable, but increasingly complex therapies in the pipeline will demand more efficient processes in the future.

An increasingly complex development pipeline and industry considerations, such as sustainability, are leading to a greater need for more efficient separation and purification in downstream processing.

The past year of downstream processing has brought innovations in pH sensitive antibody purification, single-use fermentation separators, and more.

Flexible and efficient methods are needed for biopharmaceutical manufacturing.

Emerging drug classes are giving rise to challenges in downstream processing, pushing the need for strategizing efficiencies.

Enhancement of resin technology can improve the ability of chromatography to purify the growing landscape of increasingly complex biomolecules.
Understanding the process and product goals is just the first step to a holistic approach to process development.

New biologic modalities, such as cell and gene therapies, pose increasing difficulties in viral clearance testing methods.

New challenges in extractable and leachable studies for cell and gene therapy products.

Recent innovations in chromatography resins offer promising advantage in downstream bioprocessing.